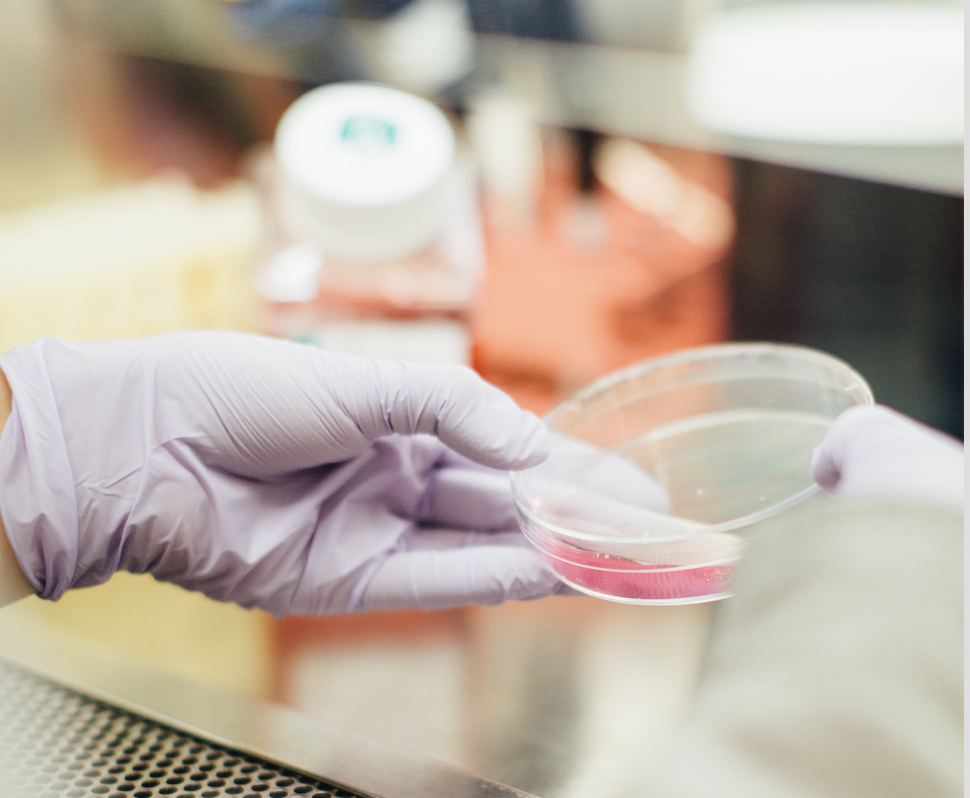

Makeup brands big and small are going green – and it’s about time.
We’re so happy to see such a drastic shift in the personal care market. It seems like every new product that launches today touts natural ingredients made & grown right here on this beautiful Earth, just like all of us.
It’s a huge step in the right direction, but what do we need to know about the toxic ingredients that still exist in all that “natural” makeup & skincare?

Petrol
Did you know there are petrol products in approximately 22% of your makeup and skincare products? According to the Environmental Working Group, while the ingredient is quite common in makeup and skincare products alike – often showing up in lipstick, moisturizer, sunscreen, cleansers – it’s both extremely toxic and readily absorbed by our skin.
The biggest concern with Petrol? Cancer.
Petroleum may be contaminated with a harmful toxin called Polycyclic Aromatic
Common Terms for Petroleum in products – as posted here.


Heavy Metals
Most people don’t think about metal in their makeup, but the fact is that most eyeshadow, mascara, concealer, foundation, lipstick
Mineral Makeup is no exception.
While Mica and Mineral Makeup have taken criticism lately for the truly horrific mining practices, which most often involve child and slave
Here’s a screenshot from Safe Cosmetics which outlines the dangers associated with the use of products containing heavy metals.


Phthalates
You may not know what a Phthalate is, but you’ve been using them your whole life.
Phthalate is a blanket term given to a group of chemicals that make plastics and other textiles soft & flexible. Up until 1994, they were heavily used in cosmetics and skincare, until they were found to pose serious health risks and even cause birth defects to children exposed to them in the womb.
Now banned in Canada, these chemicals are heavily used in many cosmetics and skincare products produced internationally, and they still make up a large portion of our packaging.


Hormone Disruptors
We’ve learned so much about how disease relates to our hormones in the last 25 years. We don’t just think of Estrogen as it relates to women in their 50’s who suffer through hot-flashes, sleepless nights, and rogue hair growth.
We now know that our hormones are directly affected by our environment & what we put on our skin.
We know that certain Cancers and other diseases feed off Estrogen & the immune-compromised position that imbalanced hormones can create.
Why aren’t we doing more to eliminate Hormone Disruptors in our Makeup & Skincare?

Carcinogens
Speaking of Cancer and Beauty — let’s talk about Carcinogens in self-care products. Sounds like an oxymoron, doesn’t it?
“Cancer-Causing Self-Care”
The sad fact? It’s no laughing matter. Most of the big makeup & skincare brands use ingredients that are known to cause Cancer. Yep, you read that correctly.
The sad truth. They just don’t care.
Known Carcinogens, like “Carbon Black”, a common
These percentages are self-reported by the companies that produce them.
Food For Thought: What if you use more than 1 product containing Carcinogens?

Skin Irritants
You know that saying, “what doesn’t kill me only makes me stronger.”?
That’s not true when it comes to self-care products.
All those Parabens, Phthalates, Heavy Metals & Petrol? Your skin doesn’t like them either – in fact, they may be the cause of your breakouts, dull or dry skin, or even advanced aging.
While many of the ingredients above make products last longer on the shelf or easier to use, many of them actually damage and irritate your skin.
The biggest offenders?
- Heavy Metals like Titanium Dioxide and Iron Oxides
- Parabens
- Phenoxyethanol & Other Phthalates
- Chemical Fragrances, which usually include Petrol
Do you feel let down by the cosmetics industry?
So did we, and that’s how Geti Cosmetics & Skincare got started.
We’re on a mission to change the beauty industry – and the world – for the better.
It all starts with truly natural products made for you to wear & share with those you love.
What makes Geti products so special?
We create top-quality makeup and skincare that’s good for you and the environment.
What don’t we add?
- Toxic Chemicals
- Petrol
- Heavy Metals
- Phalates
- Carcinogens
- Hormone-Disruptors
- Parabens
- Skin Irritants
Have a question about skincare or a skin concern/issue you want help to resolve?
Leave us a comment below or send an email to geticosmetics@gmail.com. Your question could help other people facing the same things! Help us change the beauty industry for the better.
Check out these unforGETIble Reviews from people just like you who are Geti Ready!
[arrow_forms id=’179′]
Have you already tried Geti?
We’d love to know what you think in a comment, review in the store, or email to our support team! Create a post on social media and tag @geticosmetics for a chance to win beautiful prizes each month.
References:
Petroleum & Cosmetics – Safe Cosmetics
Petroleum in Beauty Products – Goop
Mineral Makeup & Mica – LeafTV
